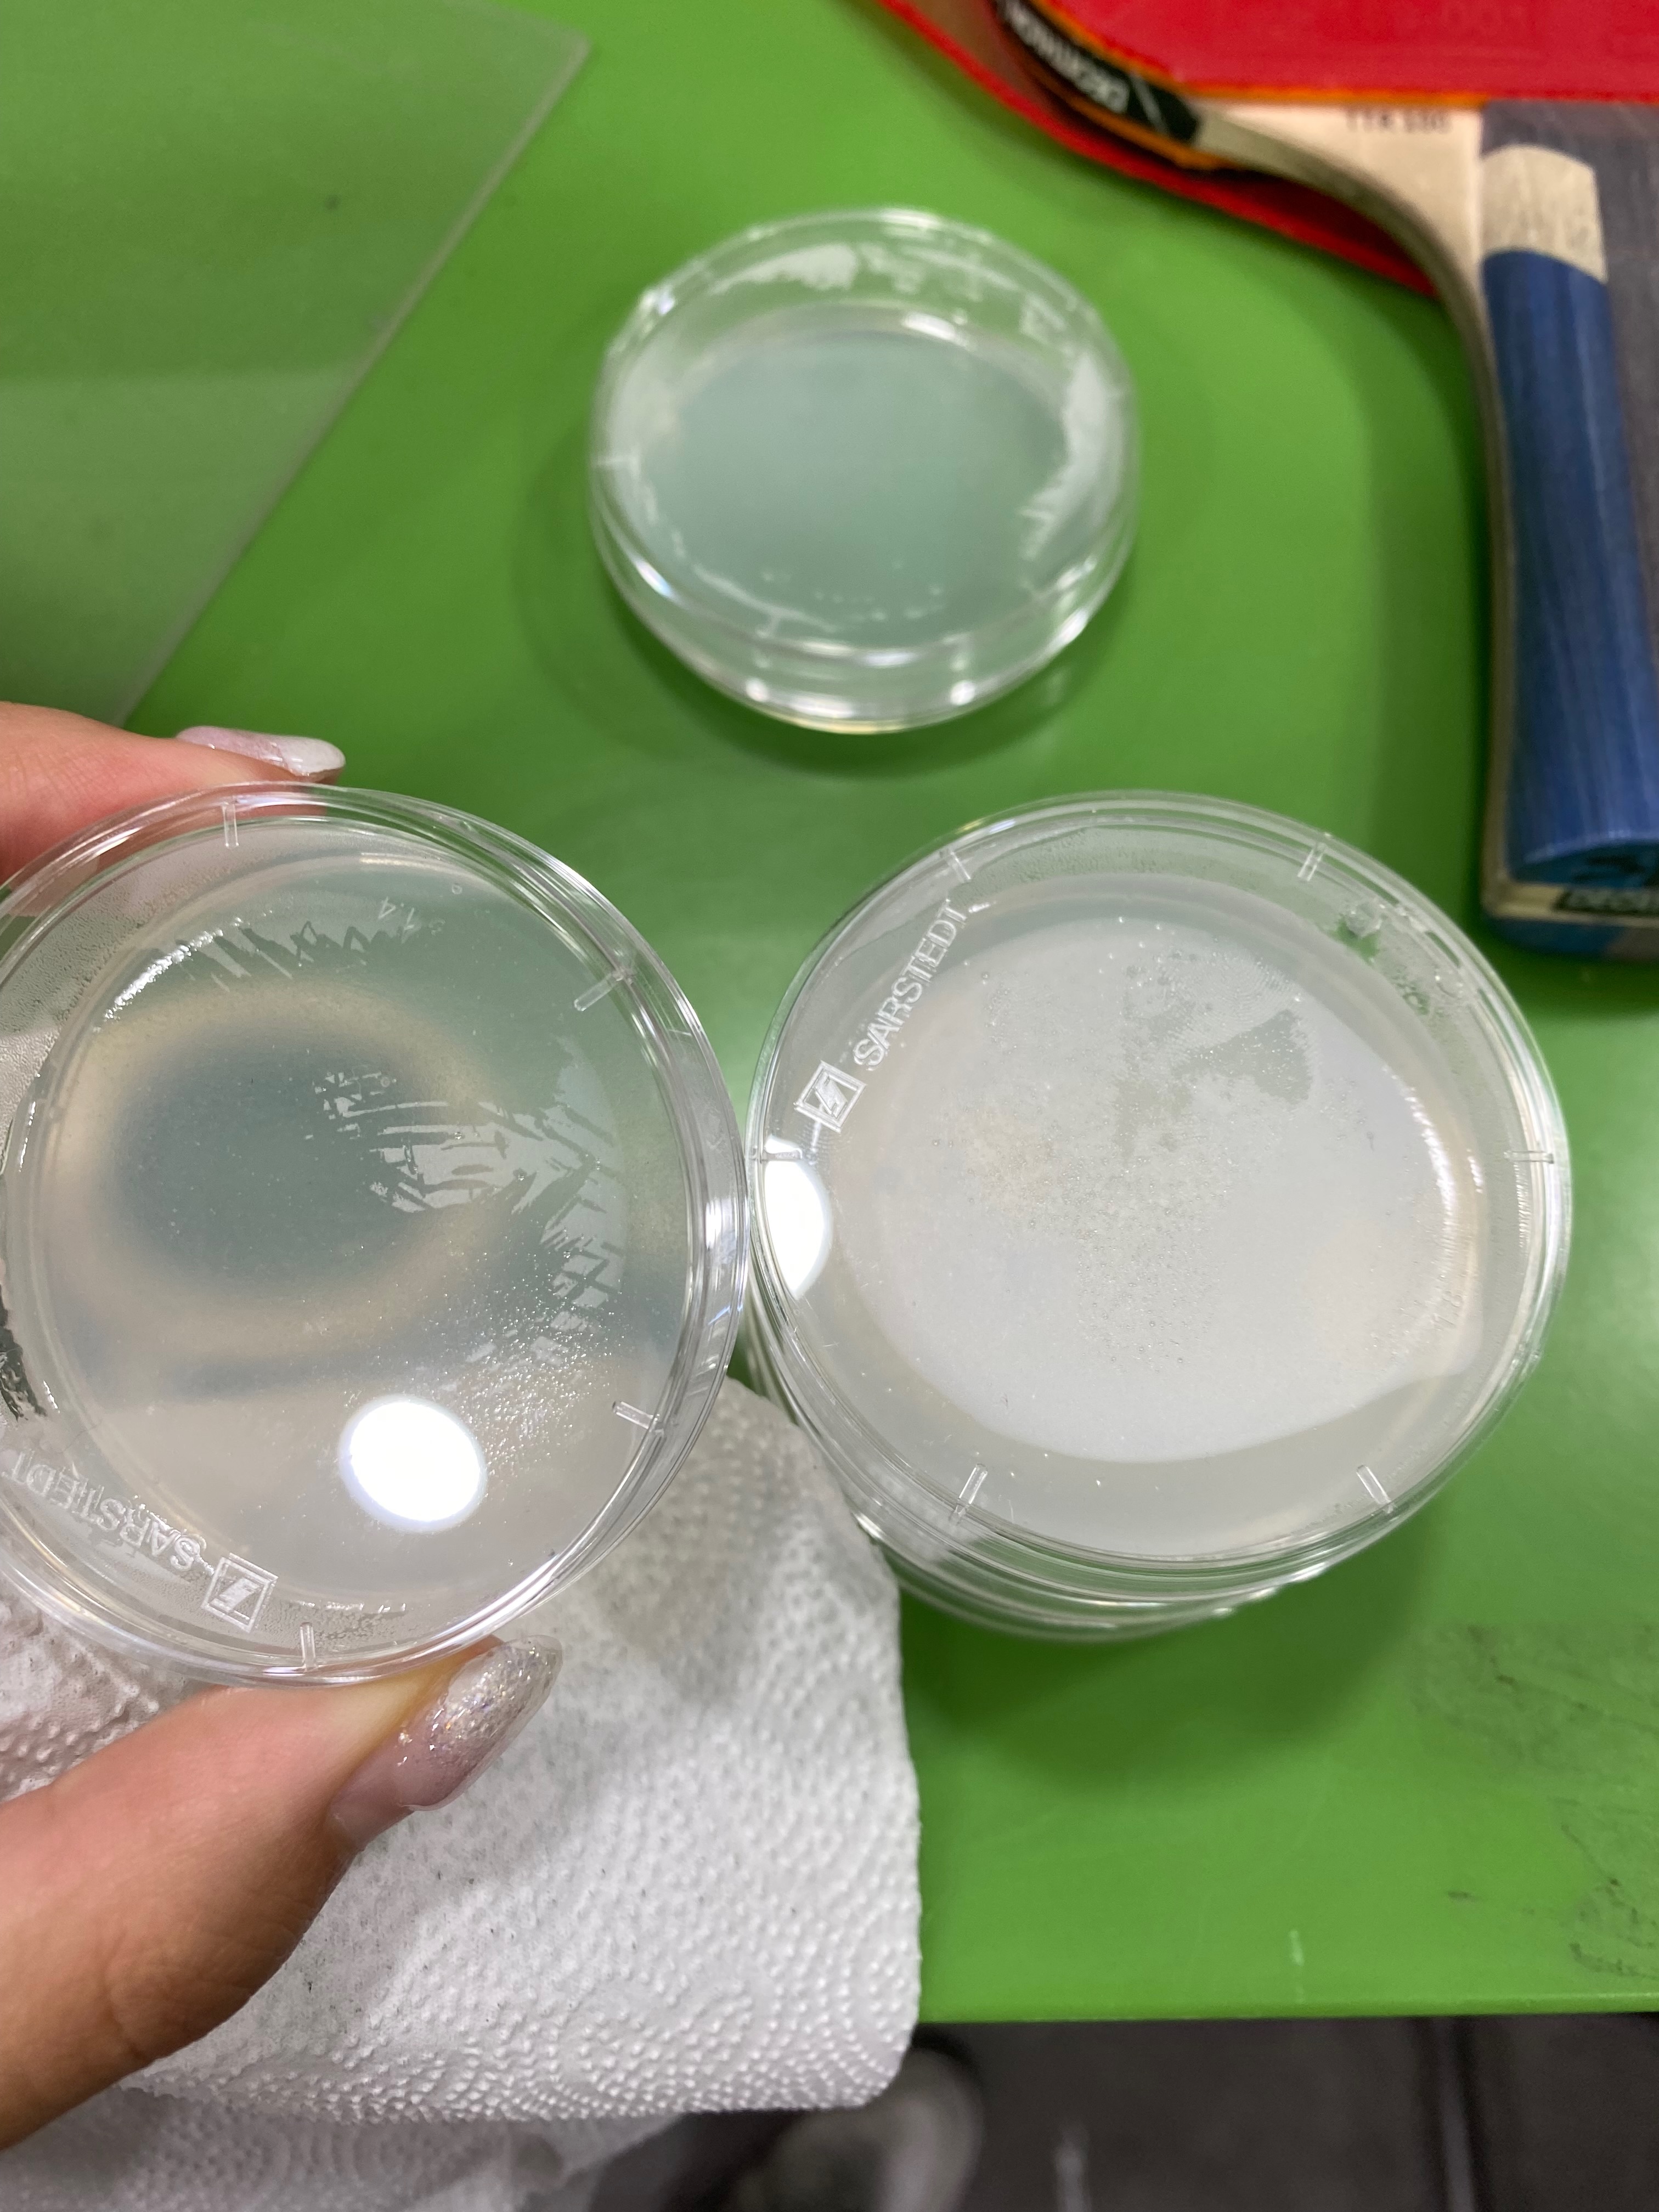
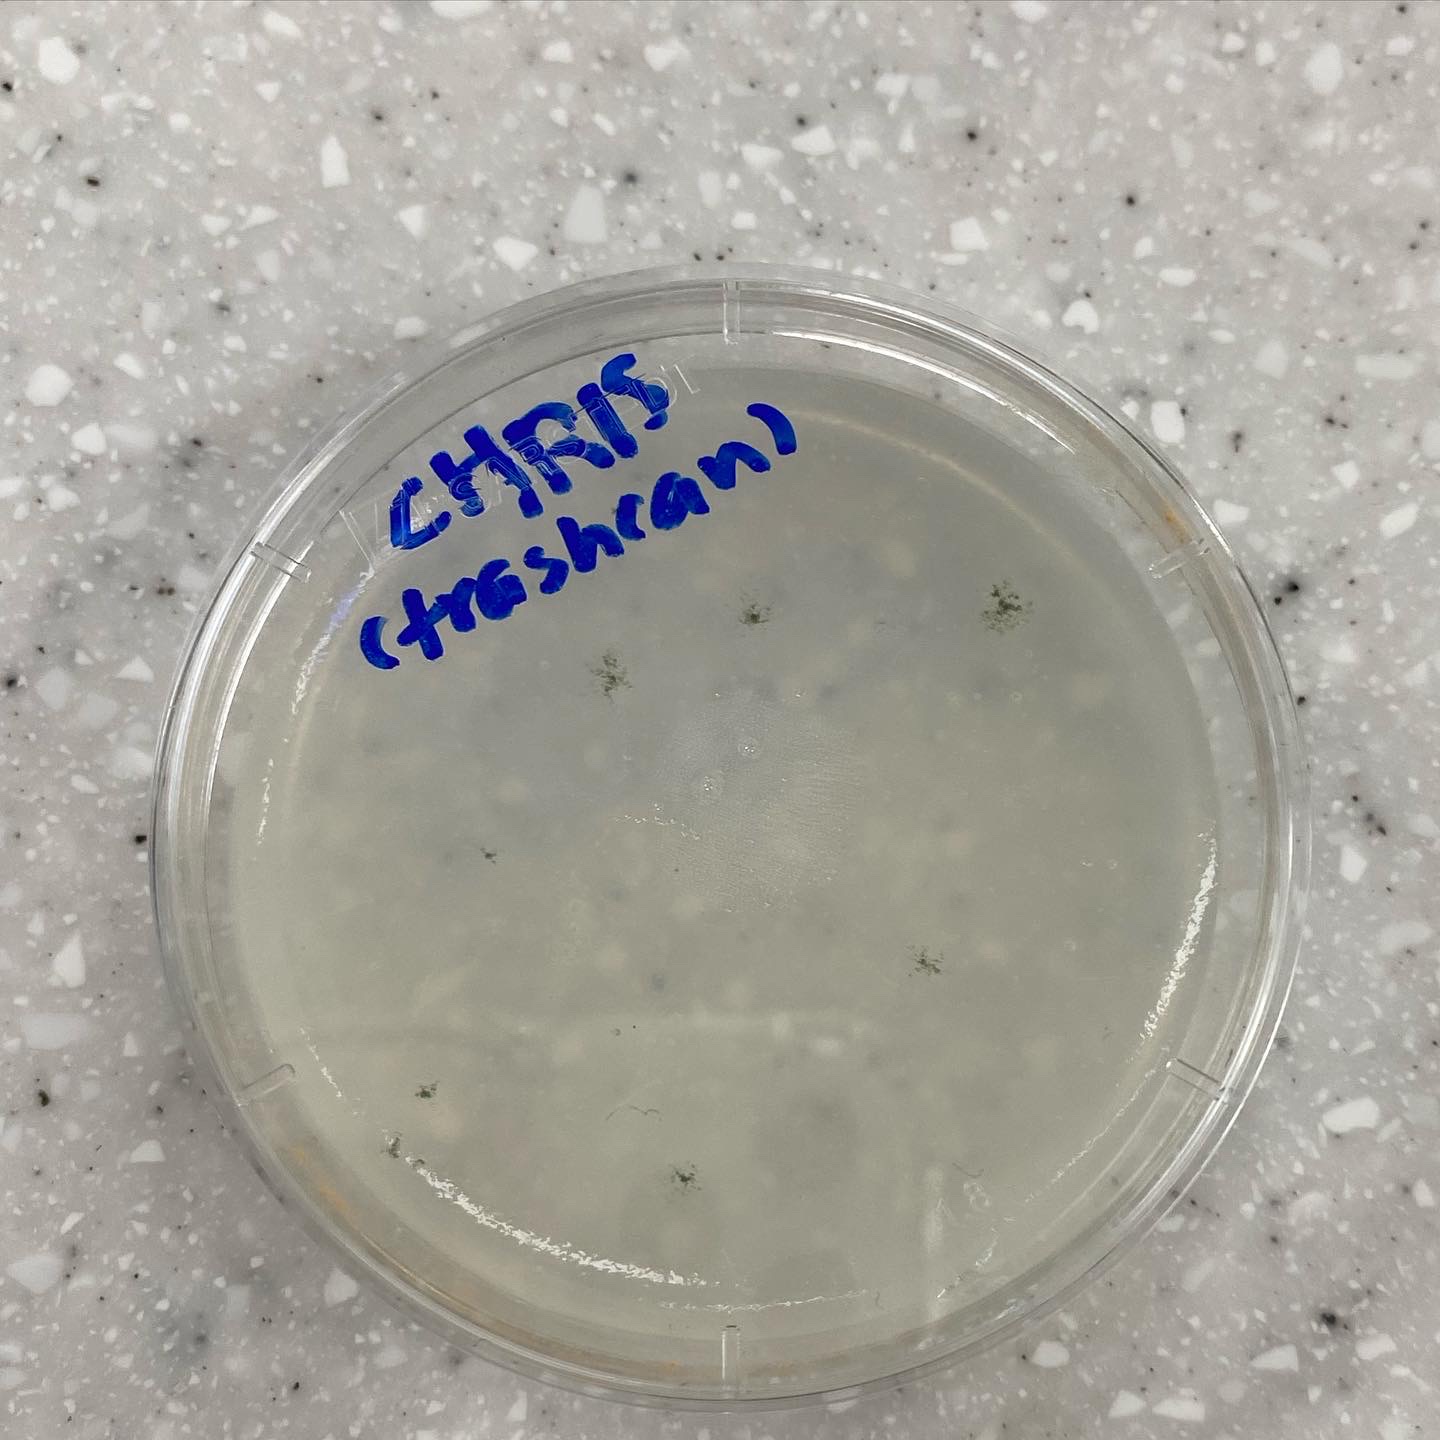
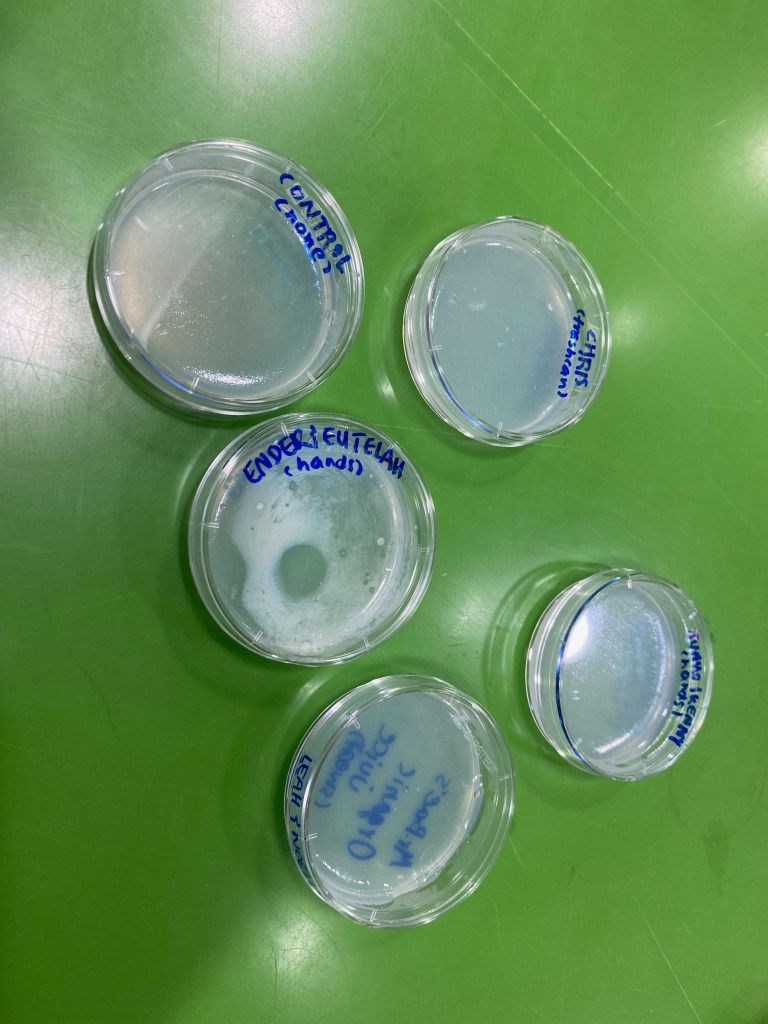
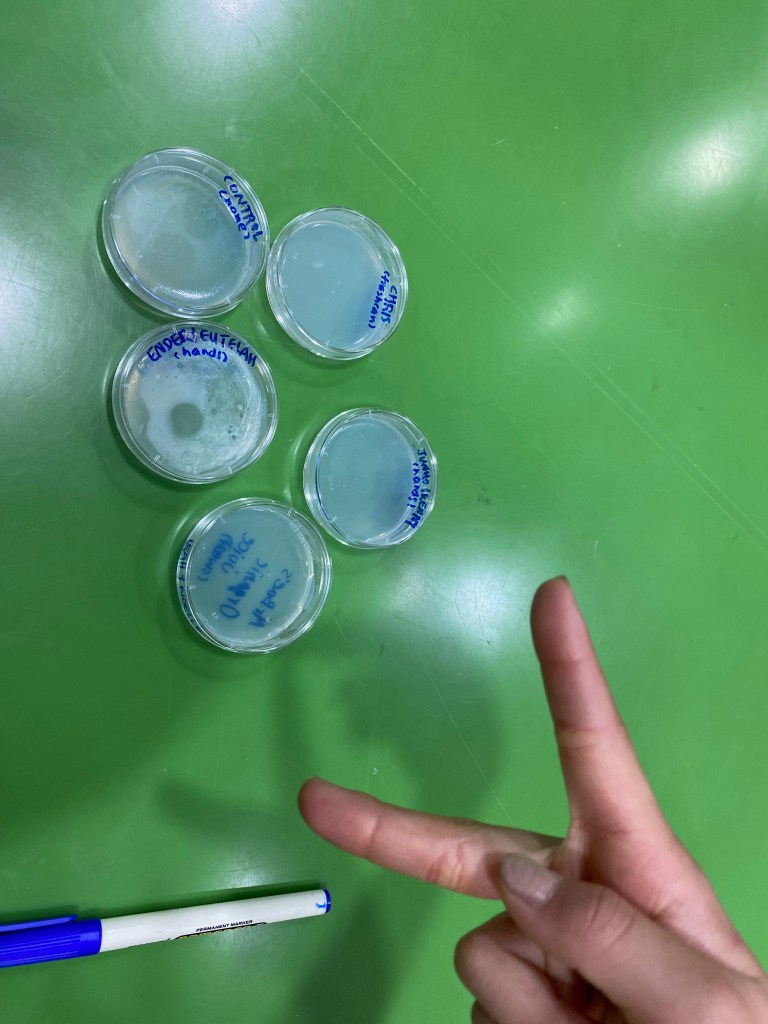

Bacteria cultivation time! Today’s lesson was kind of nostalgic in the sense that it reminded me of my CRISPR experiments, when I failed to successfully create the perfect agar petri dishes. I remember when I accidentally over-microwaved my glass bottle, which was filled with agar powder and water, and having to remake the entire solution again by matching the concentrations. Or, when I closed the lids of the petri dishes too early before it all cooled down that eventually condensation formed, and contamination occurred. When I first conducted the experiment, I remember placing my watery petri dishes into the fridge to freeze the water rather than wiping the water off in case of contamination, which actually worsened the agar situation since the frozen agar would melt and form more water, affecting the concentration.
Anyway, we created petri dishes for class today and explored different types of bacteria. The process of making the agar solution itself is extremely simple: mix 25g of agar powder and 100g of water, put it in the microwave, and let it cool down before pouring it into the petri dishes.
After the agar gel cooled down, the kids were told to swab q tips on surfaces they were curious about, and swab the q-tips onto the petri dishes. I taught them how to swab the q-tips on the surface of the agar gel, like how I learned from my biology teacher. Contrary to my expectations, some students actually swabbed very odd surfaces — one of the teacher’s sweat after PE class.
Here are the photos from today’s class:
A few days later, here are the results of the cultivated dishes:
Aaaand a comparisson.

Funny enough, the students were afraid of bringing their petri dishes home because they thought the bacteria could invade their homes haha (the after effect of watching too many movies ^^)
– Joanna Kim, August 9th, 2022, 9:53 PM KST –